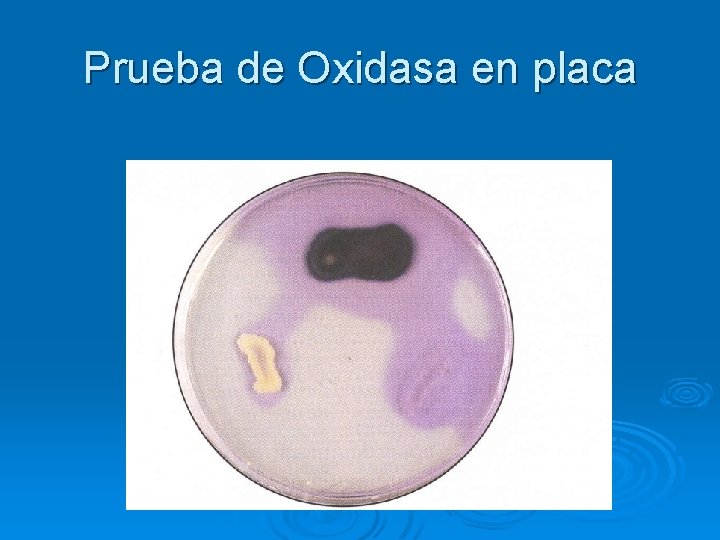
Prueba de Oxidasa en placa

Cocos Gram Negativo Neisseria spp M Paz Microbiologa

Cocos Gram Negativo Neisseria spp M. Paz Microbiología UMG-2014

Familia Neisseriaceae Ø Géneros l Neisseria • Patógenos humanos l l Kingella Eikenella Simonsiella Alysiella

Género Neisseria Ø Único reservorio: ser humano Ø Dos especies patógenas l N. gonorrhoeae • Gonorrea l N. meningitidis • Meningitis epidémica/meningitis meningocóccica Ø Muchas especies no patógenas habitantes del tracto respiratorio.

Género Neisseria Ø Neisser (1879) l Describió al agente causal de la gonorrea Ø Leistikow & Loeffler (1882) l Cultivo por primera vez Ø Weichselbaum (1887) l l l aisló a N. meningitidis de LCR de un paciente con meningitis purulenta endémica, epidémica y meningococcemia estado de portador

Género Neisseria: Morfología Ø Ø Ø Aerobios Cocos Gram Negativo No móviles Crecen en parejas No formadores de esporas Los cocos individuales son pequeños (0. 8 x 0. 6 µm) l Ø Tienen forma de riñón (lados planos adyacentes) Citoplasma y pared celular son similares entre las dos especies y similitud de ADN de 70%

Género Neisseria: Morfología Pared celular: tiene una capa densa y una membrana externa Ø Meningococos: tienen cápsula de polisacáridos y pocos plásmidos Ø Gonococos: no cápsula y sí contienen plásmidos Ø Ambas especies forman colonias convexas, brillantes y mucoides de 1 -5 mm. Ø Medios de crecimiento: agar chocolate y CO 2 al 5% Ø

Características de cultivo Crecen mejor en condiciones aeróbicas. Ø La mayoría oxidan carbohidratos, producen ácido pero no gas. Ø Producen oxidasa. Ø Susceptibles a ácidos grasos y a metales traza contenidos en la peptona y en el agar (se contrarresta con sangre, suero, almidón o carbón) Ø l El agar “chocolate” es más adecuado

Características de cultivo Baja Resistencia a condiciones físicas y químicas Ø Sufren autólisis Ø Susceptibles a desecación Ø Ø Oxidasa l (+) Oxidan rápidamente DPD o TPD (dimetil o tetrametil para fenilendiamina) • Produce un color de rosado a negro en las colonias

Género Neisseria: Metabolismo Organismo Crece en agar sin sangre Crece a 22°C Oxida Glucosa Oxida Maltosa Oxida Sacarosa N. meningitidis - - + + - N. gonorrhoeae - - + - -

Neisseria meningitidis

Neisseria meningitidis Ø Usualmente habita en la nasofaringe sin causar síntomas (microbiota transitoria) Ø Desde la nasofaringe acceden a la sangre y causan meningococcemia Ø Complicación: meningitis Ø Meningococcemia grave: fulminante, fiebre elevada y exantema hemorrágico, CID y colapso circulatorio (Waterhouse. Friderichsen)

Patogenicidad y virulencia de N. meningitidis • Mediada por los pili • Colonización específica de receptor de las células no ciliadas de la nasofaringe • Cápsula antifagocítica de polisacárido que le permite diseminarse en ausencia de inmunidad específica. • Efectos tóxicos mediados por hiperproducción de lipooligosacárido Ø Serogrupos A, B, C, Y, W 135 responsables de 90% de todas las infecciones

Patogenicidad y virulencia ØReceptores para las fimbrias bacterianas (gangliósido GD 1) sobre las células columnares epiteliales no-ciliadas en la nasofaringe del hospedero. ØLos m. o. son internalizados en vacuolas fagocíticas, evitando la muerte intracelular. ØReplicación intracelular y migración al espacio subepitelial donde libera fragmentos de membrana. ØHiperproducción de endotoxina (lípido A) y se disemina al ambiente circundante (espacios subepiteliales, torrente sanguíneo): causa la mayoría de manifestaciones clínicas de daño vascular: daño endotelial, vasculitis, trombosis, CID.


Epidemiología Ø Diseminación persona-persona vía aerosolización de secreciones respiratorias Ø Más alta incidencia en niños menores de 5 años, personas institucionalizadas y pacientes inmunodeficientes Ø Meningitis y meningococcemia: serogrupos B y C Ø Neumonía: serogrupos Y y W 135 Ø Infecciones en países subdesarrollados: serogrupo A • Mayor incidencia en las épocas frías y secas del año en todo el mundo (Se presenta en ondas)

Diagnóstico • Muestras: LCR, sangre y aspirados petequiales • Frote de Gram: difícil cuando hay pocos m. o (centrifugar y obtener sedimento para la tinción) • Cultivo: en agar chocolate o TM en jarra con candela a 37 C • Identificación: Oxidasa y pruebas de oxidación de carbohidratos


Cultivo l Medio selectivo de Thayer Martin • Agar chocolate con Vancomicina (inhibe a Gram +), Colistina (inhibe a Gram -), Nistatina (inhibe hongos) y Trimetoprim (inhibe a Proteus spp que ocasiona swarming) • Las colonias requieren 48 -72 horas para crecer. l Medio alternativo: Agar Lewis Martin agar (similar al TM, pero usa anisomicina en lugar de nistatina, para inhibir mejor a Candida albicans).

Cultivo en jarra con candela

Cultivo de N. meningitidis

Enfermedades asociadas con Neisseria meningitidis ØDespués de la diseminación de organismos virulentos de la nasofaringe: ü Meningitis ü Septicemia (meningococcemia) con o sin meningitis ü Meningoencefalitis ü Neumonia ü Artritis ü Uretritis


Infecciones por MGC Ø Síntomas: fiebre alta, escalofríos, dolor muscular y rash petequial (típico de infecciones por MGC) Ø Enfermedad puede ser crónica, moderada o fulminante. l l Tipo fulminante: Síndrome de W-F con CID, hemorragia dentro de la piel, glándulas adrenales y otros órganos. Muerte rápida por la toxemia generalizada y el shock.

Rash Petequial

Síndrome de Waterhouse. Friderichsen

Prevención y Tratamiento • Inmunidad pasiva por lactancia • Droga de elección: penicilina • Drogas alternativas: cloranfenicol, ceftriaxona y cefotaxima. • Quimioprofilaxia para contactos: rifampicina o sulfadiazina • Inmunoprofilaxia: vacuna (no efectiva para el serogrupo B)

Prevención y Tratamiento • Vacunas de polisacárido conjugado para niños menores de 2 años (18 meses). • Serogrupos A, C, Y y W-135 • No se muy inmunogénica ni confiere inmunidad prolongada l Vacuna conjugada con el toxoide diftérico • Autorizada para 11 -55 años


Neisseria gonorrhoeae

Neisseria gonorrhoeae Ø Único hospedero natural: humano Ø Portador asintomático es el mayor reservorio. Ø Edad más afectada: 15 -24 años Ø Patogenia: gonorrea l l Uretritis Cervicitis

Generalidades de Neisseria gonorrhoeae Ø Fácilmente transmitido por contacto sexual Ø Diplococos Gram-negativo achatados por el lado de unión. Ø Fastidiosos, capnofílicos y susceptibles a temperaturas frías, a la desecación y a ácidos grasos. • Requiere medios pre-calentados complejos • El medio debe llevar almidón soluble para neutralizar la toxicidad de los ácidos grasos • Crece mejor en atmósfera húmeda suplementada con CO 2 Ø Produce ácido de la oxicación de glucosa, pero no de otros azúcares.

Diagnóstico, tratamiento y prevención Ø Ø Ø Ø Tinción de Gram es precisa en muestras masculinas. Cultivo: diagnóstico definitivo Biología molecular Tratamiento: Cefixima, Ceftriaxona, Ciprofloxacina y ofloxacina en casos no complicados. Penicilina debe evitarse porque ya se presenta mucha resistencia. Doxiciclina y Azitromicina en casos complicados con Chlamydia sp. Profilaxia de conjuntivitis neonatal: nitrato de plata 1% Prevención: educación (ETS) NO HAY VACUNA

Crecimiento de GC en. MTM

Oxidasa positivo
Prueba de Oxidasa en placa

Prueba de Oxidasa en papel

Identificación Bioquímica l Para diferenciar entre las especies de Neisseria y B. catarrhalis. • Pruebas de utilización de carbohidratos. • Oxidación de Carbohidratos l Se usa un Agar Cistina-Triptosa (CTA) con azúcares. Requiere una inoculación grande e incubación sin CO 2 y observación por 24 -72 horas. • Resultados: GC: + para glucosa solamente

Azúcares en CTA

Epidemiología de la Gonorrea Ø Serio subregistro Ø Diferencia epidemiológica entre hombres y mujeres Ø Mayor reservorio: portador sintomático Ø Transmisión sexual Ø No hay inmunidad protectora para la reinfección (en parte por la diversidad antigénica de las cepas) Ø Mayor riesgo de enfermedad diseminada en pacientes inmunocomprometidos.

Mujeres Hombres Riesgo post-exposición (1 contacto) es de 50% Riesgo post-exposición (1 contacto) es de 20% Frecuentemente asintomática y sin dx Mayoría: sintomático (95%) Principal reservorio es la portadora asintomática Infección genital primariamente en el cervix, pero también son colonizados la vagina, la uretra y el recto. Infección genital restringida a la uretra con descarga purulenta y disuria Infecciones ascendentes en 10 -20%: salpingitis, abscesos tubo-ováricos, enfermedad inflamatoria pélvica, infertilidad por infección crónica. Complicaciones raras: epididimitis, prostatitis y abscesos periuretrales. Infecciones diseminadas más comunes: Infecciones diseminadas muy raras septicemia, infección de la piel y articulaciones (1 -3%) Puede infectar al infante durante el parto: conjuntivitis, oftalmia neonatorum Más común en hombres homosexuales/bisexuales que en la población heterosexual

Patogenia de Neisseria gonorrhoeae Ø Bacterias fimbriadas se adhieren al epitelio de la membrana mucosa intacta Ø N. gonorrhoeae tiene capacidad de invadir membranas intactas o piel con abrasiones. Ø Adherencia al epitelio mucoso Ø Penetración y multiplicación antes de pasar a través de las células epiteliales de la mucosa Ø Establecimiento de la infección en la capa subepitelial Ø Sitios más comunes de inoculación: • Cervix (cervicitis) o vagina en la mujer • Uretra (uretritis) o pene en el hombre

Factores de virulencia asociados a Neisseria gonorrhoeae

Gonorrea

Ophthalmia neonatorum

Significancia clínica del GC • Infecciones complicadas l l Ocurren más frecuentemente en mujeres Diseminación del cérvix a las trompas de falopio • Endometritis • Salpingitis • Peritonitis (EIP) • Ocurre en 10 -20% de mujeres infectadas • Síntomas: dolor abdominal bajo, flujo cervical y vaginal anormal, útero blando. • Puede resultar en infertilidad o en embarazo ectópico.

Salpingitis

GONOCOCCEMIA Ø Presencia de N. gonorrhoeae en el torrente sanguíneo que puede llevar al desarrollo de una infección gonocóccica diseminada (IGD). Ø Ocurre en aprox 0. 5 -3% de pacientes con gonorrea.

Manifestaciones clínicas Ø Cuadro bifásico: l Fase temprana • • • l Tenosinovitis Artralgias Dermatitis Fase localizada • Artritis séptica Ø Complicaciones: osteomielitis, meningitis, endocarditis, síndrome de dificultad respiratoria y shock séptico fatal

Pacientes a riesgo Ø Mujeres embarazadas o menstruando Ø Personas con inmunodeficiencias l l l Deficiencia de complemento Enfermedad por VIH Lupus Eritematoso Sistémico

Fisiopatología Ø Diseminación del gonococo desde un sitio primario como el endocérvix, la uretra, la faringe o el recto hacia la sangre y luego a un órgano final. Ø Usualmente son infectados múltiples sitios l Articulaciones y piel Ø Depende de cambios fisiológicos del paciente y de factores de virulencia del GC

Cambios fisiológicos Ø Cambios en el p. H vaginal l Menstruación Embarazo Puerperio Ø Edad con más incidencia: l l Hombres con 20 -24 años Mujeres de 15 -19 años

Factores de virulencia Ø Pili y fimbrias: adherencia a las superficies mucosas Ø Evasión de la fagocitosis Ø Proteínas de membrana externa (P 1, P 2 y P 3) Ø Lipooligosacárido (LOS): resistencia a la bacteriólisis Ø Cepas productoras de Proteasas de Ig. A ayudan a la supervivencia del GC en las mucosas

Diagnóstico diferencial Ø Manifestaciones cutáneas de hepatitis Ø Meningococcecia Ø Artritis reactiva Ø Artritis psoriática Ø Sífilis Ø Dermatitis (acanthosis nigricans)

Diagnóstico Ø Recuento de leucocitos: Leucocitosis l 10, 000 -15, 000/µL Ø VSE: medianamente elevada Ø Cultivo positivo: usualmente de sitios de mucosas: faringe, uretra, cérvix o recto. Ø Los hemocultivos son negativos en su mayoría (sólo 20 -30% son +) Ø Métodos moleculares (PCR)

Tratamiento Ø Hospitalización para tratamiento inicial Ø Antibióticos intravenosos por 24 -48 horas Ø Luego se cambia a terapia oral. Ø Terapia empírica inicial: cefalosporinas de tercera generación –ceftriaxonaØ Cambio a Penicilina G o ampicilina si es susceptible.

Moraxella catarrhalis

Moraxella catarrhalis Ø Ø Ø Diplococo gram-negativo Aerobio y oxidasa positivo Ha sido objeto tanto de cambios en la nomenclatura y clasificación taxonómica como de su consideración de comensal o patógeno. Actualmente, es aceptado como el tercer patógeno más importante en el tracto respiratorio humano después de Streptococcus pneumoniae y Haemophilus influenzae. En los últimos 20 años, esta bacteria ha emergido como un importante patógeno causante de infecciones en el tracto respiratorio superior de niños y ancianos, e infecciones del tracto respiratorio inferior en adultos con enfermedad pulmonar obstructiva crónica (EPOC). Aproximadamente, el 90% de las cepas son productoras de ß-lactamasas.

Moraxella catarrhalis Micrococcus catarrhalis Ø Neisseria catarrhalis Ø En 1970, basándose en la diferencia en el contenido de ácidos grasos y mediante estudios de hibridación de ADN se demostró la escasa homología que existía entre N. catarrhalis y las llamadas "verdaderas" especies de Neisseria, estando, más cercana al género Acinetobacter. Así pues, fue reclasificada y transferida al género Moraxella Ø

Moraxella catarrhalis Actualmente, el género Moraxella engloba cocos y bacilos cortos relacionados genéticamente Ø Bovre propone su división en dos subgéneros: Branhamella, que englobaría los cocos y Moraxella para los bacilos cortos. Ø Algunos autores prefieren el nombre de Branhamella catarrhalis Ø l l Las otras especies de Moraxella son bacilos cortos, mientras que M. catarrhalis son diplococos M. catarrhalis es un importante patógeno del tracto respiratorio humano, mientras que las especies de Moraxella rara vez causan infección en humanos.

Patogenia de Moraxella catarrhalis Ø En niños: l l Otitis media Sinusitis Bacteremia Meningitis Ø En adultos: l l l exacerbaciones en pacientes con EPOC neumonía en ancianos infecciones nosocomiales.

Factores de virulencia de Moraxella catarrhalis Ø LOS (Lípido A) Ø Peptidoglucano Ø Proteínas de la membrana externa Ø Fimbrias Ø Cápsula Ø Proteínas reguladores del hierro Ø Resistencia al complemento

Diagnóstico de Moraxella catarrhalis Muestras clínicas: Gram, Cultivo y pruebas bioquímicas Crece en medios comunes, como agar sangre y agar chocolate, Ø Colonias redondas, opacas, convexas y de color gris. Ø Los criterios más usados para su identificación son los siguientes: Ø Ø l l l Ausencia de pigmentación en agar sangre (no hemolítica). Producción de oxidasa y catalasa. Producción de DNAasa. Hidrólisis de la tributirina. Ausencia de producción de ácido a partir de glucosa, maltosa, sacarosa y fructosa. Reducción de nitratos y nitritos.


Tratamiento de Moraxella catarrhalis Ø Las cepas de M. catarrhalis son uniformemente sensibles a las quinolonas, amoxicilina-clavulánico, cefalosporinas, ticarcilina, piperacilina, macrólidos, cloranfenicol y aminoglucósidos. Ø Se han comunicado casos aislados de cepas resistentes a las tetraciclinas, eritromicina, fluoroquinolonas, macrólidos, piperacilina y a algunas cefalosporinas
- Slides: 64